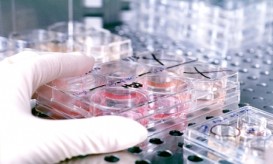

Είναι ασφαλές το ρόφημά σας αν πέσει μέσα μια μύγα ή ένα κουνούπι; Δείτε την απάντηση!…
Σε όλους μας έχει συμβεί κάποια στιγμή να δει μία μύγα ή ένα κουνούπι να πέφτει μέσα στο ποτήρι...
Σε όλους μας έχει συμβεί κάποια στιγμή να δει μία μύγα ή ένα κουνούπι να πέφτει μέσα στο ποτήρι...

Το φονικό κουνούπι-τίγρης χρησιμοποιεί τις εθνικές οδούς για την εξάπλωσή του από περιοχή σε περιοχή, ανακάλυψαν ερευνητές στον Παναμά...

Μπορεί να ήρθε ο Σεπτέμβρης αλλά ο ιός του Δυτικού Νείλου είναι ακόμη εδώ. Τι καταγράφουν οι ειδικοί του...

Το βίντεο που ακολουθεί καταγράφει τον τρόπο που ένα κουνούπι δαγκώνει το υποψήφιο θύματου.Κατά μέσο όρο, το κάθε ένα...

Ανησυχία επικρατεί και στις υγειονομικές αρχές για τον ιό του Δυτικού Νείλου μετά την επιβεβαίωση του πρώτου κρούσματος σε...

Μετά από σχεδόν 98 χρόνια η Ευρωπαϊκή ήπειρος βιώνει πάλι, τον εφιάλτη του Δάγκειου πυρετού. Αυτή τη φορά από...

Οι επιστήμονες δεκαετίες τώρα, προσπαθούν να βρουν έναν αποτελεσματικό τρόπο για να καταπολεμήσουν τον Δάγκειο πυρετό. Μέχρι στιγμής όλες...

Ασθενής 84 ετών από το Αγρίνιο πέθανε από αιμορραγικό πυρετό και σηπτικό σοκ, αφού προσβλήθηκε από τον ιό του...

Την πιο μεγάλη κρίση με οσμή αδιαφάνειας, φαίνεται ότι καλείται να αντιμετωπίσει το υπουργείο Υγείας (εκτός από την κρίση...
Ακόμα έναν πονοκέφαλο προκαλεί στον Ανδρέα Λυκουρέντζο η υπόθεση των αντιδραστηρίων για τον μοριακό έλεγχο για τον ιό του...

Εκατοντάδες περιστατικά από τον ιό του Δυτικού Νείλου με βαριά αλλά και ασήμαντα συμπτώματα αναμένουν οι ειδικοί του ΚΕΕΛΠΝΟ...

Και δεύτερος νεκρός από τον ιό του Δυτικού Νείλου καταγράφεται μέσα σε λίγες ημέρες. Όπως έγινε γνωστό από το...

Καθημερινά οι ειδικοί του ΚΕΕΛΠΝΟ συνεχίζουν να καταγράφουν νέα περιστατικά του ιού του Δυτικού Νείλου με τους περισσότερους ασθενείς...

Τα στοιχεία για τα κρούσματα από κουνούπια, του ιού του Δυτικού Νείλου, έδωσε το ΚΕΕΛΠΝΟ. Σύμφωνα με τους επιστήμονες,...

Σε απόλυτο συναγερμό βρίσκονται πλέον οι αρμόδιες υγειονομικές υπηρεσίες μετά τον πρώτο θάνατο από τον ιό του Δυτικού Νείλου...